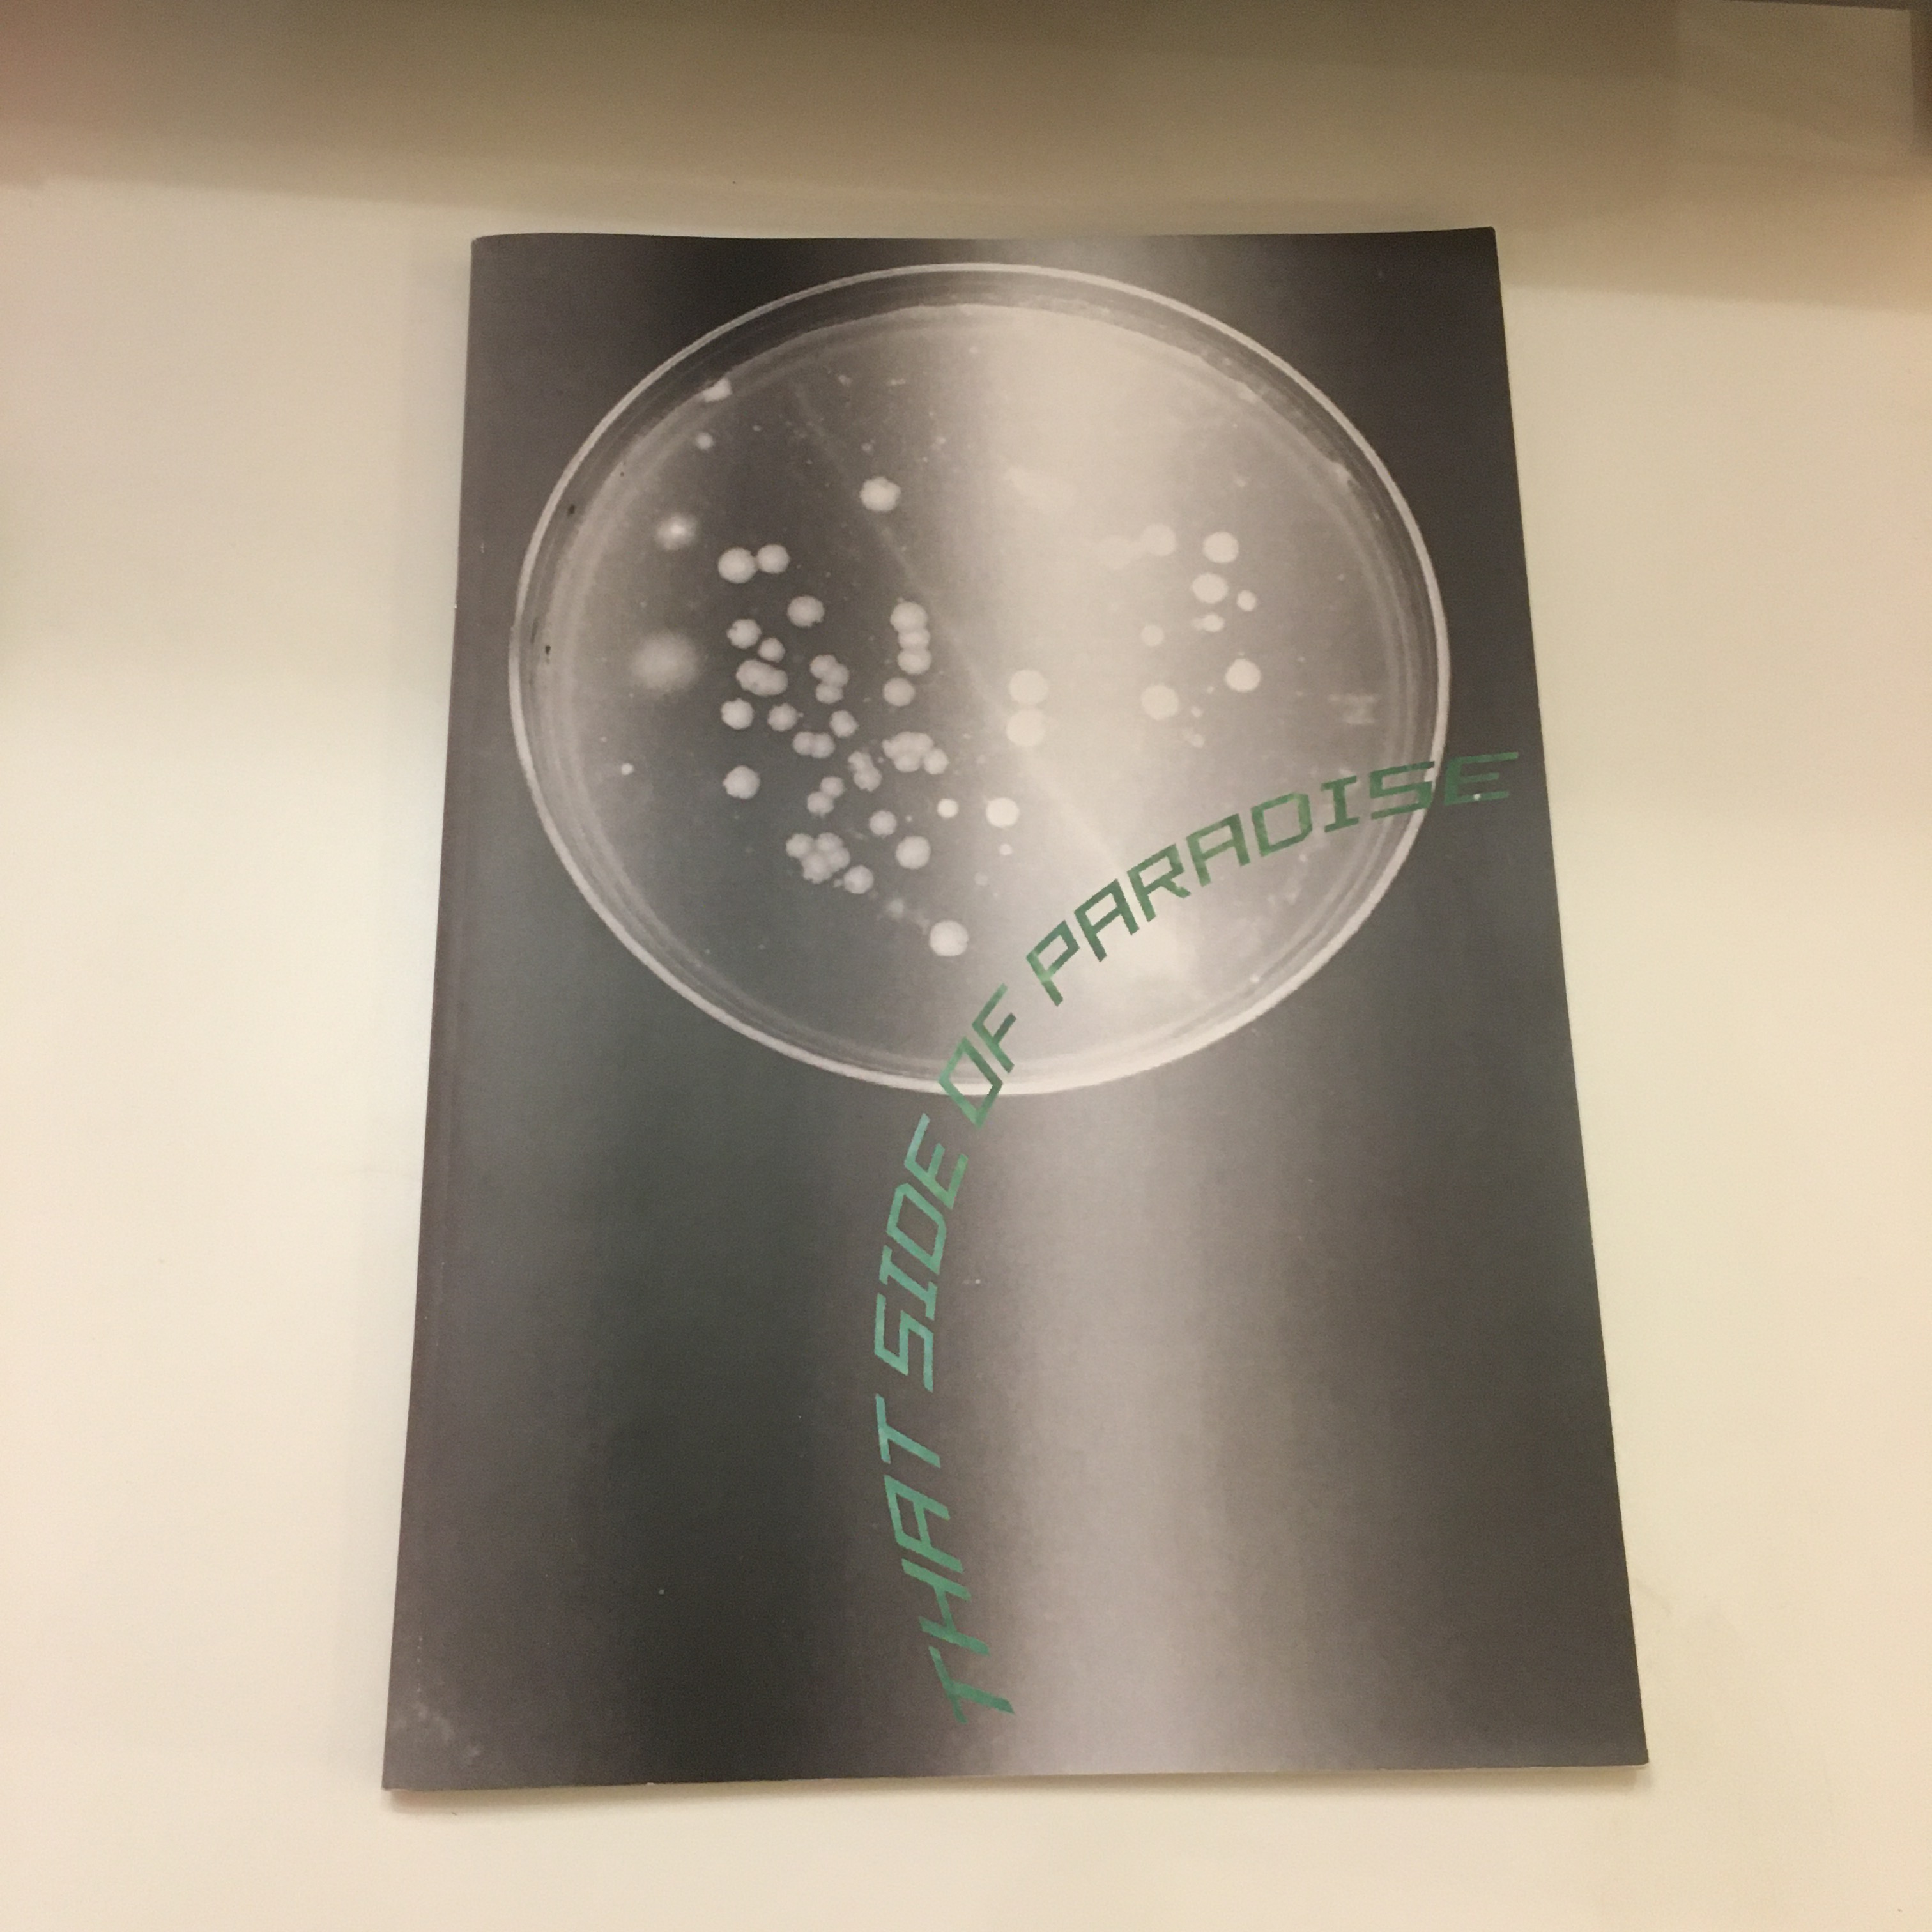

Some you may have seen that in the spring of 2020, several of my works were published in “That Side of Paradise” issue of Seagery Zine. Here are a few shots from my personal copy.
Well this month Katrina Vera Wong who runs the Seagery Zine outdid herself! In the midst of the COVID-19 pandemic, she ventured into learning a new technology and created a virtual exhibition titled “BLANK”. Here is the summary:

You can check out the whole exhibition here, but I will show you a few shots right in this post.
My work is in the upper left image. These images can be printed on some cool merch in my RedBubble shop here and here.





A huge thank you to Katrina for setting this up!
Art is my emotional outlet and my oasis. I use art to express my feelings and work through life issues. Come join me on this journey of letting go of control and letting the creative process take over. You will get access to all of the behind the scenes footage and see the major breakthroughs that translate into new artwork.
Please join my Mailing List & receive:
- Special sneak peeks at new artworks and my creative process
- First dibs on new pieces
- And a FREE photobook of my work (by email)!
- NO spam ever!
hk

Leave a comment